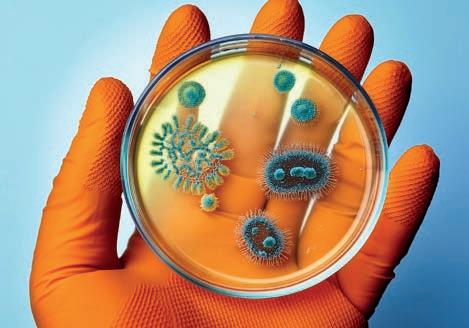

![]()






Avtorice:
Sanja Lončar, dr. Mateja
Lobe Prebil, dr. vet. med.,

Maria Ana Kolman, Jasmina Kandorfer, Sabina Topolovec in mag. Eva Nedelko




Poznate občutek, ko zjutraj telo nikakor noče »začeti z delom«? Ko se megla v glavi nikakor ne razkadi? Ko kava ne prime več?
Morda je čas, da odkrijete najbolj regenerativne rastline na planetu, ki zmorejo umiriti naš um, okrepiti telo in na naraven način povečati proizvodnjo celične energije. Odlična novica je, da obstajajo in so danes preprosto dosegljive.
Knjigo lahko prelistate in naročite na povezavi ali poskenirate QR-kodo ->
znanje.zazdravje.net

Zazdravje. net Preverjene naravne rešitve




Kot nas opozarja Karel Gržan, je ekonomija v svojem izvornem pomenu pomenila optimalno upravljanje resursov skupnosti. To, kar je ekonomija danes, pa je diktatura hrematizma, ki se izdaja za ekonomijo, z njo pa ima zelo malo skupnega.



Hrematizem v interesu peščice želi le maksimizirati dobičke in ploditi denar. Denar ni živ in je zato narobe pričakovati, da se bo oplajal. Denar se množi le tako, da se več uniči, več proda, več zaračuna ... Rast BDP zato pomeni, da za vse več stvari, storitev in pravic zdaj plačujemo, kar ustvarja napačen občutek, da smo ustvarili več vrednosti.
Marsikaj, kar je bilo včasih brezplačno, je danes plačljivo, kar je bilo poceni, je danes nekajkrat dražje, to pa nujno ne pomeni, da živimo bolje kot prej. Za ustvarjanje več denarja je treba imeti v družbi vse več težav, vse več bolezni in vse več konfliktov. S tem se »dela denar«. Žal so prav vojne in izredna stanja najbolj dobičkonosne »poslovne priložnosti«, vse kaže, da jih bo še več, saj ko »poslovni mrhovinarji« zavohajo lahek denar, sla po njem le raste.
Se bomo zmogli vrniti k pravi ekonomiji, preden uničimo vse resurse, odnose, zdravje in planet, ki nam omogočajo življenje? Premislek o novi ekonomiji se seveda začne z našo lastno energijsko in ekonomsko bilanco. Bolj obvladamo svoje lastne resurse (beri: manj težav imamo sami s seboj), manj služimo interesom dobičkarjev. Več je miru v nas in med nami, manj je priložnosti za vojne hujskače. Ko ne bomo več tako zaposleni z lastnimi težavami, utrujenostjo in strahovi, bomo lažje uzrli tudi priložnosti za veliki reset po meri nas – navadnih ljudi.
Sanja Lončar, urednica
• https://www.facebook.com/ SkupajZaZdravje/
• https://www.instagram.com/zazdravje/
• https://www.zazdravje.net
• https://znanje.zazdravje.net
• https://delavnice.zazdravje.net

Zazdravje.net
4 Hvala, ne gremo se več!
6 Ko je poslanstvo nad dobičkom
8 Okradeni, pa tega niti ne opazite?
10 Kupi manj – plačaj več!
12 Ko domneva postane zakonodaja
Zdrava medicina
14 Gora vitaminov – nič učinka?
16 Ščitnica, naš upravljavec energije
20 Varno odstranjevanje amalgamskih zalivk
22 MRSA – davek na »razvoj«?
Ščepci zdravja
19 Ali kavica da ali vzame?
Zdrava hrana
24 Kaj se skriva v hladni poslastici?
29 Od pridelka do izdelka s skupnimi močmi
30 Od kod prihajajo »slovenska« semena?
IMPRESUM:
Novice izdaja: Društvo Ognjič
Odgovorna urednica: Sanja Lončar
Kontakti: info@zazdravje.net, (041) 770 120
Fotografije: Saša Vučina, Sanja Lončar, Adobe Stock
Oglasno trženje: Jasno in glasno, d.o.o.
Oblikovanje: Saša Vučina (Opa!celica) Tisk: Schwarz print

BESEDILO: SANJA LONČAR
Denar poganja ta svet ... in ga hkrati tudi uničuje, zasužnjuje ter sili v razvoj, ki ga usmerja le potencialni dobiček za vlagatelje.
Hrana, ki je zrasla na zemlji in pod nebom, ne prinaša toliko dobička kot hidroponika in pridelava v laboratorijih. Pred kratkim je podjetje Savor ponosno predstavilo maslo, ki ga je izdelalo iz CO2 brez česarkoli biološkega. V resnici gre za termokemični proces, podoben predelavi fosilnih goriv.
Tisti, ki se vsak dan znova lahko prepričamo, kako vitalne, okusne in kakovostne so sorte, ki so hranile številne generacije in nabirale izkušnje v naših tleh, ne potrebujemo »genomsko dodelanih« semen.
Res potrebujemo otroka po naročilu in kloniranega hišnega ljubljenčka?
So za vsak šport in obliko rekreacije res nujna posebna oblačila? Moramo res plačati, da telovadimo, plešemo ali da nas kdo samo posluša in ponudi robček, da se lahko zjočemo? Na Japonskem je to razvita storitev – oseba, s katero se lahko pogovarjate in vas posluša v zameno za plačilo.
Denar je poskrbel, da je danes »monetizirano« domala vse. Narave in storitev zmanjkuje, zato je pred vrati še zaračunavanje ogljičnega odtisa in uporabe elektrike ob »napravih urah«, kmalu pa se bodo verjetno spomnili še česa.
Od kod takšna sla po zaračunavanju vsega? Preprosto iz narave obstoječega finančnega sistema, ki obstaja le tako, da ga hranimo.
Če pod današnjimi pogoji najamete posojilo za 100.000 evrov, boste v desetih letih morali vrniti 130.000 evrov. Kako boste ustvarili 30 odstotkov več, če ne tako, da povečate svoje prihodke in najdete še kaj, s čimer bi se dalo »delati denar«.
V enakem položaju je tudi država, ki si nenehno izposoja denar, da bi vzdrževala svoj obstoj. Odvisno od zadolženosti in aktualne cene denarja gre 10–20 odstotkov od vseh zbranih davkov in prihodkov države bančnikom, ki so nam »dali denar«. To pomeni, da moramo tudi vsi državljani, ki zaradi tega plačujemo vse višje davke, v cene svojih storitev in izdelkov vgraditi še tisti delež, s katerim hranimo finančne sisteme.
Tudi podjetja morajo kupovati opremo, repromaterial in prevozna sredstva, zato v ceni vsakega izdelka vse večji odstotek pomenijo stroški kreditov, lizingov, bančnih garancij, provizij ... V vsem, kar kupimo, dejansko dobršen odstotek le »hrani denar«.
Vrhunec takšne lakote denarja so sanje bančnikov, da digitalizirajo vse naše transakcije z digitalno valuto (CBDC), ki jo bodo lahko nadzirale, dovoljevale ali prepovedovale in neposredno tudi obdavčevale.
Denar ne ustvarja denarja – ustvarjati ga moramo ljudje. Mi smo tisti, ki ustvarimo nekaj vrednega
za druge ljudi, in to lahko počnemo z denarjem ali brez njega. Prej bomo to dojeli, prej bomo videli številne možnosti za družbo obilja, ki ne bo usmerjena le v to, da hrani denar.
Ko ljudje sodelujejo in izmenjujejo svoja znanja, veščine in presežke, je veriga izmenjave zelo kratka in v njej ni treba »hraniti« še kopice posrednikov in tistih, ki nam tiskajo bankovce ali na računih vpisujejo številke.
Dobro delujoče skupnosti številne potrebe svojih članov zadovoljijo, ne da bi za to potrebovale denar. Včasih nismo potrebovali patronažnih služb, hospica, varstva starejših in otrok, animatorjev za otroke ..., ker je vse to zmogla delujoča in sočutna družina. Danes vsak starostnik utopično pričakuje, da mu bo ministrstvo za socialno prihodnost dodelilo plačanega asistenta, fizioterapevta, patronažno medicinsko pomoč in brezplačne prevoze.
Danes je vse več ljudi, ki znova gradijo skupnosti, ki jih je turbokapitalizem razgradil. Nastajajo neprofitna in socialna podjetja, zadruge, kooperative in društva, ki delujejo in za osnovni cilj nimajo ustvarjanja dobička.
Ljudje se združujejo tudi zato, da bi si pomagali in skupaj dosegali, kar je za posameznika nedosegljivo ali preveč zahtevno.
Ni nujno, da se vsi vrnemo na kmetije, da bi bili prehransko varni. Lahko živimo v mestu in občasno gremo pomagat kmetom. Lahko skupaj sooskrbujemo živali ali obdelujemo skupinske njive, kot to počnejo v društvu Samooskrbni.net. Ohraniti lokalna tradicionalna semena je prevelik izziv za posameznika, če pa si delo razdelimo, kot to že počnejo v različnih društvih, lahko zagotovimo odličen semenski material in prehransko varnost za lokalno skupnost.
Ni nujno, da je vsak usposobljen za zeliščarstvo, čebelarstvo, divjerasle rastline, vlaganje in shranjevanje. Dovolj je, da imamo v skupnosti eno ali dve osebi, ki to obvladata, preostali bodo pomagali in na koncu bo vsega dovolj za vse.
Da ne omenjam, da ima vsaka slovenska hiša toliko orodja in pripomočkov, ki bi jih bilo mogoče vsaj petkrat bolj izkoristiti.
Vsa društva in organizacije, ki se ukvarjajo z modeli sobivanja, navajajo, da je to najbolj ekonomičen model, ki prinaša več blaginje za vse. V času, ko se pojavlja vse več skritih davkov v obliki plačila infrastrukture, postaja življenje manjših družin vse bolj obdavčeno.
Komunala vam zaračuna zabojnik za smeti, ne glede na to, ali ga polnijo ena, dve ali tri osebe. Znesek za internet ali TV-naročnino je enak, ne glede na to, ali v gospodinjstvu živijo ena ali štiri osebe. Novi izračun, po katerem bomo plačali predvsem angažirano moč pri elektriki, bo tudi najbolj prizadel enočlanske družine (več o tem preberite na strani 26).
Na kateri točki se bo individualnost umaknila ekonomiji skupnosti? Prej ko se naučimo sodelovati in združevati moči, prej bomo zgradili področja naše nove humane ekonomije. Bomo čakali, da nam pred tem vzamejo vse, ali se bomo zmigali, dokler je prehod še vedno lahko udoben in prijazen?

VANDANA SHIVA
»Spomnim se Zuckerbergovega govora na Harvardu. Dejal je, da bo 99 odstotkov ljudi nekoristnih.
Mogoče v vašem svetu, gospod Zuckerberg. V resničnem svetu pa lahko vsak prispeva. Ko en odstotek reče, da je 99 odstotkov neuporabnih, je čas, da 99 odstotkov reče: ‘Pravzaprav so vaše ideje precej neuporabne za nas. Ustvarili bomo lepše, ki so bolj radodarne in solidarne ter imajo več potenciala za prinašanje sreče.’«

BESEDILO: SANJA LONČAR
V času, ko razmišljamo o novi ekonomiji, ki ne bo zasledovala dobička kot končnega cilja, se lahko veliko naučimo od uspešnih podjetij, ki delujejo kot zadruge, fundacije ali zavodi.
Pri tem ne gre za marginalne organizacije z nekaj zaposlenimi. Italijanska zadruga Coop denimo zaposluje na tisoče ljudi. Weleda, ki je tudi organizirana kot fundacija, tudi zaposluje na stotine ljudi in deluje po vsem svetu. Med večjimi je tudi A.Vogel AG, družba, ki je skoraj v celoti v lasti fundacije Alfred Vogel, ki jo poznamo po učinkovitih naravnih zdravilih in prehranskih dopolnilih.
Kaj pomeni takšna organizacijska oblika za delovanje podjetja na današnjem trgu in kaj imamo od tega potrošniki, smo se pogovarjali s prof. dr. Schönslebnom, dolgoletnim predsednikom nadzornega odbora A.Vogel AG in članom vodstva fundacije Alfred Vogel iz Švice:

dr. Schönsleben
Mnogi napačno menijo, da je pri neprofitnih podjetjih cilj poslovati z nič dobička. Tudi sami smo šli skozi to fazo in ugotovili, da je takšna miselnost bližnjica do propada podjetja. Delovati brez rezerve,
brez možnosti za razvoj in nagrajevanja dobrega kadra, je tvegano. Tudi zaposleni se v takšni družbi počutijo negotovo in raje gredo tja, kjer vidijo uspeh.
Ustvarjati dobiček ni grešno. Pomembna razlika je v tem, kaj bomo z dobičkom počeli. Mi ga uporabljamo za to, da nadaljujemo poslanstvo Alfreda Vogla.
Kaj v praksi pomeni »uporabiti denar za nadaljevanje poslanstva«?
Situacija na trgu naravnih izdelkov je vsak dan bolj zapletena. Kompleksnih preparatov, ki so sestavljeni iz večjega števila rastlin, dandanes skorajda ni več mogoče registrirati, ker je treba dokazati, kakšen učinek ima določena snov v tej recepturi in zakaj mora biti notri. Sintezni pripravki, ki imajo le eno aktivno učinkovino, so tisočkrat preprostejši za registracijo. Kompleksnost narave pa je prevelika za ozkost obstoječe zakonodaje, zato bodo takšni pripravki obstali le, če jih bodo ljudje sami pripravljali ali zanje zaprosili v svoji lokalni lekarni.
Zato smo se odločili več energije posvetiti temu, kar je bilo tudi za Vogla glavno poslanstvo – ozaveščanje ljudi in širjenje informacij.
Odločili ste se za povsem nov prevod knjige Ljudski zdravnik. V Sloveniji to knjigo poznamo že pol stoletja, Zakaj jo je bilo treba prevajati na novo?
Na žalost so si v starih prevodih prevajalci dovolili preveč sprememb. Voglovi pogledi so za mnoge bili preveč »alternativni«, zato so cenzurirali, kar jim ni bilo povšeči, in celo dodajali osebna mnenja. Zato je bilo nujno narediti prevod še enkrat iz izvirnika. Menimo, da je Ljudski zdravnik osnova, ki bo ljudem omogočila, da si sami pomagajo pri številnih težavah, in je zato nujno, da je prevedena iz nemščine točno po izvirniku. Danes je to še bolj pomembno kot pred desetletji, saj je dostop do takšnih informacij vse bolj omejen.
Strinjam se z vami, da je to ena izmed redkih knjig, kjer najdemo tudi recepture in postopke, kako si pomagati pri bolj zahtevnih stanjih, ki jih danes večina ne zna več reševati brez antibiotikov in drugih agresivnih zdravil.

Prednost Voglovih pripravkov je v tem, da ne zahtevajo kakšne visoke tehnologije za pripravo. Zahtevajo pa razumevanje težave, kakovostne rastline in natančne recepture. V Sloveniji, kjer imate dostop do rastlin v naravi in hkrati verjetno največ ljubiteljskih zeliščarjev na prebivalca v vsej Evropi, me ne skrbi, da številnih pripravkov, ki jih ni več mogoče kupiti, ne bi znali narediti sami.
Vrnimo se na delovanje podjetja
A.Vogel AG. Kako ste konkretno organizirani? In kako stimulirate zaposlene, da sledijo temu poslanstvu?
A.Vogel AG je organiziran kot družba, ki je v 95,2-odstotni lasti neprofitne fundacije. V fundaciji ni plačanih delovnih mest, pazimo pa, da so med člani odbora fundacije v večini tudi vodilni ljudje podjetja. S tem zagotavljamo, da so odločitve fundacije življenjske in omogočajo optimalno upravljanje družbe. Smo tudi v stiku z nekdanjimi direktorji, ker modrost in izkušnje, ki so se nabrale skozi vsa desetletja, še vedno štejejo.
Presežke fundacija investira drugače kot bi kapitalistični lastnik. Tudi v neprofitne zadeve, razvoj, raziskave, založbo. Eden od večjih projektov je tudi obnova hiše Alfreda Vogla in zeliščnega vrta v Teufnu.
Takšen način delovanja ima še eno prednost –omogoča, da družba deluje brez dolgov in kreditov, kar pomeni, da nismo odvisni od tekočega financiranja bank, razen za kratkoročne projekte, ki jih hitro zapiramo. Mi lahko trdno spimo. Banke nas ne morejo prevzeti, kot se dogaja z večino podjetij, ki so prezadolžena.
Prednost je tudi to, da ne potrebujemo finančnega direktorja, ki bi se nenehno ukvarjal z bankami, iskanjem denarja ... Ne boste verjeli, koliko denarja v drugih podjetjih gre za to in koliko v ceni vsakega izdelka predstavlja plačilo obresti za izposojen denar, garancije, financiranje zalog ... Govorimo o ogromnih vsotah denarja, ki danes obremenjuje gospodarstvo in seveda tudi ceno, ki jo plača končni uporabnik.
Denar torej ni težava Kako pa je z drugimi viri? Z dobavami?
Kako spremembe vremena vplivajo na vaše dobavitelje?
Naša dobavna pot se začenja v naravi. Če ne dobimo prave arnike ali dobimo samo eno desetino, kako bomo naredili Atrogel?
V nasprotju s podjetji, ki delajo s sinteznimi snovmi, je naša proizvodnja zelo občutljiva. Odvisni smo od letne žetve.
Naša največja prednost, da delamo po načelih Alfreda Vogla in uporabljamo sveže rastline v času vse bolj intenzivnih podnebnih sprememb, postaja tudi naš največji izziv.
Da se izognemo izgubam zaradi toče, neurij, poplav in podobnih okoliščin, rastlin ne smemo gojiti le ne eni lokaciji. Namenoma drobimo pridelavo na veliko različnih lokacij, da znižamo tveganje, da bi ostali brez rastlin. To je logistično bolj zahtevno, kot če bi vse, kar potrebujemo, pridelali na eni veliki površini.
Različne lokacije, posebej če so oddaljene, pa ustvarjajo druge zaplete. Kako svežo rastlino v nekaj urah pripeljati od daleč? Včasih to ni izvedljivo, zato moramo delati izvlečke na mestu pridelave, kar pomeni, da potrebujemo na več mestih vsaj del predelovalnih obratov.
Druga možnost je, da hitro pripeljemo sveže rastline na sedež podjetja, kar je logistično tudi zapleteno in drago.
Ohranjati svežino je ena od najdražjih zahtev naše proizvodnje. Če se bodo ekstremni vremenski pojavi nadaljevali, bo to vse večji izziv. Ali bodo ljudje pripravljeni plačati za najvišjo kakovost ali bodo raje posegali po izdelkih, narejenih iz posušenih rastlin, ki bodo cenejši, četudi za ceno manjše učinkovitosti, je vprašanje.
Ohranjanje svežine postaja vse dražje. Kaj mislite, zakaj nihče na svetu ne dela zeliščne soli po metodi Alfreda Vogla? Receptura za Herbamare je javna, lahko bi nas kopiral, kdor hoče. Pa ni nobenega. Veste zakaj – ker je postopek toliko dražji in bolj zapleten od konkurenčnih zeliščnih soli, da se tega preprosto nihče ne loti.
Mi delamo tako, kot je to zastavil Alfred Vogel –rastline, zelišča in zelenjavo maceriramo v soli, da ta iz njih potegne nase vse dragocene sestavine, in potem odparimo presežno vodo. Vse dobro ostane ujeto v soli.
In zakaj drugi tega ne počnejo? Ne zveni zapleteno?
Če bi danes začenjali, si tega ne bi mogli privoščiti. Težava s takšnim delovanjem je predvsem v koroziji. Sol in fermentacije skupaj so uničevalci opreme. Prav v tem je največji izziv, kako to delati, da ti ne razžre cevk, posod, tesnil ...
Je pa Herbamare razred zase.
Zanimivo je, da je med korono prodaja izjemno poskočila, ker so ljudje kuhali doma in so hoteli najboljše. Zdaj, ko jih ponovno hranijo gostilne in obrati hitre prehrane, je vodilo predvsem dobiček, zato se prodaja tisto, kar je najcenejše.
Kako pa zagotavljate zadostno količino izdelkov navkljub nihanju količin pri pridelavi?
Osnova večine naših produktov so tinkture. Na srečo so te, če so narejene in skladiščene pravilno, zelo stabilne in jih lahko uporabljamo več let. Zavestno pa tudi pridelamo precej več, kot pričakujemo, da bomo lahko prodali, ker v negotovih časih preprosto moramo imeti rezervo.
Podjetja, ki zasledujejo le dobiček, tega ne bi počela, ker bi vse, kar ne bi bilo uporabljeno v določenem času, zavrgla. Če pa je naš cilj predvsem varnost in poslanstvo, potem je takšno dejanje za nas smiselno.
Če ne bi imeli takšnih rezerv, se ne bi mogli prilagoditi desetkratnemu dvigu povpraševanja po zdravilu Echinaforce v času covida-19.
To so bila logistično zelo zahtevna leta. Iskali smo in odkupovali ves pridelek s polj z ekološko pridelavo ameriškega slamnika po Evropi.
Da svojim podizvajalcem zagotovimo varnost, smo sprejeli obveznost, da najprej odkupujemo rastline z njihovih polj. Naša lastna pridelava je rezerva in če imajo partnerji dobro letino, bodo naša polja ameriškega slamnika ostala bolj za okras.
Če delaš s svežimi rastlinami, moraš vedno pridelati veliko več, kot zares potrebuješ. Zato takšno delo pa tudi dobički niso primerljivi s sinteznimi pripravki in tega podjetje, ki zasleduje le dobiček, nikoli ne bi počelo.
Hvaležni smo, da smo organizirani tako, da ne odstopamo in se držimo načel Alfreda Vogla.

BESEDILO: ANA HAUSER
Velikokrat smo že pisali o novih načinih, kako kupcu vzeti več in ponuditi manj, on pa tega ne opazi. Verjetno že poznate pasti skrčfilacije (manj izdelka v enaki embalaži). Izognete se ji le tako, da v trgovino hodite s povečevalnim steklom (ali telefonom) in namesto velikih številk za cene dosledno berete ceno na kilogram ali kos, ki je zapisana zelo drobno pod ceno izdelka.
Večji dobiček mnogi proizvajalci dosežejo tudi tako, da spremenijo sestavo in vam v enaki količini dejansko dajo manj. Prej je sok denimo vseboval 30 odstotkov sadnega deleža, preostalo sta bila voda in sladkor. Zdaj pa v enaki količini za enako ceno dobimo 20 odstotkov sadnega deleža. Vse je legalno, vse piše ... Da vi pričakujete to, kar ste dobili pred letom dni, je pa vaš problem.
Več o tem boste brali tudi v besedilih v nadaljevanju. Zdaj pa si oglejmo nekaj manj opaznih načinov, kako vam vzamejo več za manj vrednosti.
Če ne morejo spremeniti obsega, pa so mnogi spremenili rok uporabe izdelka. Če ste prej belo tehniko uporabljali tudi po 15 ali 20 let, so proizvajalci zdaj poskrbeli, da bodo novi izdelki veliko krajšega življenjskega veka. V vsakem se najde kakšen občutljiv delček, ki »crkne« prej in se ga »ne splača zamenjati« ali pa popravilo stane skoraj toliko kot nov izdelek. Novi multipraktik iste znamke, kot sem jo imela včasih, je zdaj narejen iz veliko tanjše pločevine in plastike, ki poči že, ko jo grdo pogledaš. Ribanje korenčka na njem je za rezilo preveč in največ, kar premore, so zrela jabolka. Mlinčki za kavo, ki jih uporabljam za začimbe, drug za drugim »crkujejo«, ker je rezilo iz ultratanke pločevine, ki je le zlepljena. Včasih pa je to bila kompaktna kovina z navojem.
Tudi zaradi vse bolj »ošvohnelih« paličnikov se ne smemo pritoževati. Ti so namenjeni, da zmiksamo bučno juho za dve osebi. Petlitrski lonec pa je po mnenju proizvajalca že profesionalna raba.
Šivati na novih šivalnih strojih je tudi preveč optimistično pričakovanje. Ko se bodo plastični deli že v enem letu obrabili, vam bodo rekli, da ste ga profesionalno uporabljali, v garanciji pa je lepo zapisano, da ni namenjen profesionalni rabi.
Upate sešteti, koliko denarja ste že zmetali za izdelke, ki zdaj niso več združljivi z novo tehnologijo. Imate stari VHS-predvajalnik, kasetofon, diaprojektor, refleksnozrcalno fotoopremo, telefone starejše generacije, analogni televizor ... Vsa ta oprema je mogoče še vedno funkcionalna, pa je zaradi spremenjenih vhodov, nepovezljivosti ali drugih trikov preprosto pristala na smetišču zgodovine.
Nevidna inflacija se je pretihotapila tudi med storitve. Tako so zavarovalnice iz paketov preprosto izbrisale nekatera kritja, zadržale pa enako ceno. Banke se hvalijo z nizko ceno paketa, potem vam dodatno mastno zaračunajo še digitalno bančništvo, vsako položnico ... Hoteli pa so storitve, ki so bile
prej vključene v cene prenočitev, izločili in jih boste zdaj doplačali (na primer uporabo parkirišča, kopalnega plašča, brezžičnega omrežja, pogled na morje).

V to kategorijo sodi tudi večja poraba vašega časa za enako storitev. Če namesto štirih okenc na banki delujeta dve, so vam dejansko ukradli dvakrat več časa, ki ga porabite za čakanje v vrsti. Če bi preračunali, bi ugotovili, da se je provizija banke povišala tudi iz tega naslova.
Industrija je angažirala cele armade psihologov, da ugotovijo, koliko denarja nam lahko ukradejo, pa to še vedno pogoltnemo. Rezervirali ste storitev ali izdelek, pa je, ko ste prišli ponj, postal naenkrat dražji? Na računu je zaračunano še nekaj, česar prej ni bilo v predračunu? Cena na polici je bila nižja od tiste, ki ste jo plačali na blagajni ... »Ah, kdo bo porabil še 15 minut za te sitnosti, če smo že tako v stiski s časom?« Dejansko ponudniki točno vedo, koliko vam lahko vzamejo, ne da bi vas razkurili, in na račun tega še dodatno zaslužijo. Če se kakšnemu kupcu vseeno utrga, pa mu hitro vrnejo preveč zaračunano, ker so že dovolj zaslužili pri tistih 99, ki se jim s tem ni dalo ukvarjati.
Majhna knjiga, velika pomoč!
Odkrijte, zakaj ste utrujeni in pozabljivi, zakaj vam ni do seksa, zakaj vas napenja in zakaj vas v slabem vremenu muči slabo počutje!
Znanje.zazdravje.net


Kupi manj –plačaj več!
BESEDILO: SABINA TOPOLOVEC
Ste opazili, da so čokoladne tablice vse lažje, ko jih primete v roke? Ali banjice s sladoledom in mnoge druge jedi? Po novem za enak (ali celo višji!) znesek prejmemo manj, čeravno tega oko morda ne zazna. A to je le eden od številnih trikov, s katerimi nas želi preslepiti prehranska industrija.
Nemška potrošniška organizacija Foodwatch že od leta 2009 izbira izdelek leta z najbolj zavajajočim oglaševanjem. V letošnjem »boju za prestižni naslov« so si zmago priborili sadni »bombončki« s kar 72 odstotki sladkorja, čeprav na prednji strani embalaže preberemo podatek, da so brez sladkorja. Na drugem mestu je pristal vaniljev sladoled, ki se je ob enaki ceni skrčil kar za dobrih 30 odstotkov! Na tretjem je veganska mortadela, ki obljublja, da je narejena na osnovi sončničnih semen, v resnici pa jih vsebuje le dva odstotka! Kaj od tega pa se vam zdi najbolj grozno?
Težava je v tem, da črke na prednji strani embalaže večina lahko prebere, tiste na zadnji pa le redki! Preslepijo nas tudi lepe fotografije, ki obljubljajo eno samo zdravje!
Otroci vse pogosteje postajajo tudi potrošniki z lastno denarnico (in presojo o nakupu). V šoli po drugi strani dobivajo vse več seminarskih nalog, za katere porabijo ure in ure pred računalnikom in brskajo po internetu. Kaj pravite na idejo, da oboje združimo? Kaj, če bi jim za nalogo dali proučitev sestave jogurtov, čokoladnih namazov, kosmičev ali česa podobnega? Prepričana sem, da bi se tovrstne naloge vsi lotili z veseljem tudi v skupinah, pridobljena lastna spoznanja pa so vredna več od vsakega nasveta iz učbenika!
Vzemimo za primer vse bolj priljubljene rastlinske jogurte. Če bi jih poslali med police bolje založenih večjih trgovcev, bi na njihovi embalaži lahko našteli tudi 15 in več sestavin. Pri pouku gospodinjstva lahko razložite, da za navadni jogurt v resnici potrebujemo le mleko (ali rastlinski napitek) in ustrezno živo kulturo. Arome, gostila in drugi aditivi, škrob, dodani vitamini in ogromne količine sladkorja (različnih vrst) so le poceni dodatki, ki poskušajo zamaskirati izdelek nižje kakovosti oziroma ga prodati po višji ceni. Če gre za rastlinski izdelek, ki ni ekološki, obstaja tudi velika verjetnost, da gre za gensko modificirano zrnje. Na drugi strani pa lahko najdemo tudi kakovostne jogurte, kakršni so iz podjetja Sojade, ki so narejeni zgolj iz sojinega napitka in živih kultur – vsebujejo torej le dve sestavini. Takšnega bi lahko poustvarili tudi v gospodinjski učilnici. Znamka Sojade je na voljo tudi v bolj dovršenih različicah, v obliki grškega jogurta (ki ga

pričara zgolj dodatek pektina), jogurta skir (z dodanimi mandljevimi beljakovinami) in v različnih sadnih okusih. In zelo pomembno: uporabljena soja je ekološka, zrasla na evropskih tleh! Vse te različice so priložnost urjenja otrok v gospodinjskih veščinah, ki močno presegajo zapletene izraze iz učbenika za gospodinjstvo! Znanje za življenje, skratka!

Tablice Lifebar so kakovostne beljakovinske ploščice, narejene pretežno iz oreščkov in semen, suho sadje pa poleg arome igra tudi vlogo sladila.
Tudi proteinske tablice so jed, ki bi se je otroci z veseljem lotili v šoli in pozneje doma. Če bi sledili sestavinam, ki jih najdemo v večini tovrstnih izdelkov, bi poustvarili kvečjemu sladkorne in ne proteinske tablice. Fruktozno-glukozni sirup na prvem mestu je neizpodbiten dokaz, da v takšni tablici težko najdemo dober in zadosten vir beljakovin, ki nam ga sicer tako sveto obljubljajo. Poleg tega te pogosto izvirajo iz soje neznanega porekla ali mleka oziroma sirotke v prahu. Vse skupaj pa je bogato začinjeno z aromami, barvili in konzervansi. V resnici za kakovostno beljakovinsko ploščico potrebujemo le nekaj oreščkov in semen ter suho sadje kot sladilo. Najbolj kakovostnim izdelkom iz trgovine pa dodajajo kvečjemu nesporne riževe ali grahove beljakovine (na primer tablice Lifebar). Žal trgovci želijo izdelek, s katerim je mogoče največ zaslužiti, zato je tiste zares dobre izdelke težje najti v široki ponudbi.
IN ZDRAVIH RECEPTOV!
Če niste med tistimi, ki v trgovino hodijo z lupo, ali med tistimi, ki ne kupujejo predelanih izdelkov, vam torej preostane le eno: »Lonček, kuhaj!« Doma,
v miru, iz sestavin, ki jih sami odmerite. Tako bo sestava vselej jasna, glavni šef pa kar vi! In to je tisto, k čemur vas spodbujamo že več kot 20 let z novicami, videoposnetki, predavanji, delavnicami in knjigami! A ljudje smo v poplavi informacij, tudi teh, ki vam jih posredujemo mi, vse bolj izgubljeni. Vse bolj iščemo čistost, preglednost, predvsem pa preverjene informacije na pladnju! Že leta nas prosite za izčiščeno knjigo, v kateri vam na enem mestu ponujamo naše najbolj priljubljene recepte, takšne, ki so zdravi, preprosti in predvsem – hitro pripravljeni! Zato smo to poletje resnično zavihali rokave: v pripravi je knjiga, ki vam bo vse to omogočila!
Dotlej pa si lahko pomagate z našo uspešnico Zdravilna moč začimb za otroke z zakladnico slastnih in zdravih receptov, v katerih še kako uživajo tudi odrasli.
Dobitnikom letošnjih treh »nagrad« iz drugega odstavka v preizkušnjo priporočamo naslednje recepture iz omenjene knjige, ki nikakor ni zgolj za otroke: energijske žele bombone (str. 220), sladoled zdravosned (str. 172) in pašteto, polno sonca (str. 158). V omenjenih bombonih je sladkorja okoli 40 odstotkov, prav takšen pa je tudi delež sončničnih semen v pašteti! Banjico sladoleda lahko brez slabe vesti napolnite do vrha in še čez!
Naj vam bo pri ustvarjanju v kuhinji toplo pri srcu. Gostom pa svojih kreacij kljub vsemu ne postrezite s pridevniki »zdravo, polnovredno, dobro za srce …«. Dovolite, da jih prepriča okus (in verjemite, da jih bo). Recept in knjigo pa jim pokažite šele takrat, ko zanju zaprosijo!


BESEDILO:
SANJA LONČAR
Vse se začne z napačno domnevo, da naravne in sintezne snovi v telesu delujejo enako.
Za stroko je enako, če uživamo gensko pridobljen sintezni vitamin C ali takšnega, ki ga pridobivajo s tuši acetona v nikljevem katalizatorju, prah acerole ali limonado iz domačih limon.
ENAKE, KAJ PA V TELESU?
Že o tem, kako so vrednosti postavljene, bi lahko veliko razpredali. Dejansko je pri številnih vitaminih in rudninah nemogoče prešteti, kaj ljudje že imamo v telesu in koliko to, kar uživamo, bilanco povečuje. Znanstveni izračuni zato temeljijo na vrsti težko preverljivih predpostavk, končna številka pa je rezultat barantanja med odločevalci in ponudniki prehranskih dopolnil.
NISMO VSI ENAKI
Med količino zaužitega in uporabljenega so razlike včasih tudi tisočkratne, zato morajo nekateri zaradi oslabljenega mikrobioma, šibkih jeter ali drugih razlogov zaužiti veliko večje odmerke od dnevno priporočenih, da sploh dosežejo učinek.
Poznam kar nekaj ljudi, ki dnevno uživajo tudi po 20.000 enot kakovostnega vitamina D, pa imajo še vedno vrednosti pod spodnjo priporočeno mejo.
Naravni viri, četudi mogoče ne vsebujejo velikih količin posameznega vitamina, pridejo v paketu z drugimi snovmi, ki učinek pomnožijo. Podobno se dogaja tudi pri prehranskih dopolnilih, ki v recepturi kombinirajo različne vitamine in rudnine za dober učinek.
Birokratski pogled na vitamine sistematično dela krivico naravnim izdelkom. Tisti, ki niso želeli dodati sinteznih vitaminov, ker potem izdelek ne more imeti ekološkega certifikata, na embalaži ne smejo navajati trditev, vezanih na vitamine, ki so v izdelku naravno prisotni. Ker gre za naravni izdelek, je namreč nemogoče natančno zapisati, koliko je vitamina v izdelku, in to med celotnim trajanjem roka uporabe. Čeprav so številna živila že po svoji naravi odlični viri vitaminov, rudnin, antioksidantov, proizvajalci ne smejo navajati nobenih zdravstvenih trditev. Tisti, ki v izdelke zapakirajo dobro mero sinteznih vitaminov, pa lahko na veliko razglašajo učinke, četudi je stvarna biorazpoložljivost včasih minimalna.
Vitaminizirani izdelki so postali ena od modnih muh prehranske industrije, ki je ugotovila da če v vodo doda nekaj vitaminov, to lahko proda dražje kot vino in sadne sokove, zato je trg preplavljen s tako imenovano funkcionalno hrano, ki povsod doda kakšen vitamin in rudnino, da s tem ustvari dodano vrednost.
Za množično rabo seveda uporabljajo najcenejše sintezne vire vitaminov, zato so tudi učinki temu primerni in pogosto nezaželeni. Za sintezna vitamina A in E so študije že večkrat pokazale, da v presnovi ti dragoceni antioksidanti razpadejo na snovi, ki se vedejo oksidativno, kar je ravno nasprotno temu, kar z vnosom želimo doseči.
To, na kar so mnogi zagovorniki naravnih snovi opozarjali, je zdaj potrdila tudi stroka. Nekateri sintezni vitamini, kot je vitamin A, lahko poškodujejo jetra (hepatotoksičnost) ali so celo teratogeni (povzročajo genske in funkcijske poškodbe ploda v nosečnosti).
Raziskave, narejene na sinteznih snoveh, pa se –zaradi prve napačne predpostavke o identičnem delovanju – potem posplošijo in znova postanejo zakonodaja za vse.
Torej, sintezni vitamin A, ki ga pridobijo iz nafte in je – nič kaj presenetljivo – sporen, je zdaj omadeževal tudi tiste vitamine A, ki so pridobljeni iz povsem naravnih virov. Tudi izolirani betakaroten, pred katerim zagovorniki naravnih rešitev že dolgo svarijo, da ima lahko številne stranske učinke, je v strokovnem mnenju, ki ga je pripravila EFSA, označen kot potencialno nevaren za kadilce, ker lahko spodbudi nastanek pljučnega raka.
Tisti, ki nas že dolgo berete, se mogoče spomnite, da smo o tem pisali že pred desetletjem, ko smo opozarjali, da karotenoidi delujejo najbolj učinkovito in varno, če uživamo celoten spekter, ne le izolirani betakaroten. Zato upamo, da ne boste napačno sklepali, da bo več korenčka in ohrovta v prehrani povečalo nevarnost, da zbolite za rakom!
Regulatorji se še vedno ne bodo spuščali na kakovost različnih virov vitaminov in rudnin v prehranskih dopolnilih.
Z zamejevanjem dnevnega vnosa, ne da bi vedeli, kakšna je biorazpoložljivost tega, kar uživamo, potrošnik ne bo nič bolj zaščiten. Tudi prehranska industrija s tem ni dobila nobenih novih omejitev, razen da v enem izdelku ne bo smela dodajati vitaminov v večjem odmerku od dnevnih.
Koliko takšnih izdelkov boste zaužili na različnih koncih, pa nihče ne bo preverjal.
Uredba bo najbolj prizadela tiste uporabnike, ki za doseganje terapevtskega učinka potrebujejo večje odmerke vitaminov. Iz prakse številnih naturopatov je namreč razvidno, da so bili pri odpravi nekaterih težav za dosego cilja potrebni bistveno višji odmerki, kot velja za priporočene odmerke.
Številne vitamine v telesu sistemsko uničujejo zdravila, mikrovalovna sevanja, protibolečinske terapije in oslabljena črevesna flora. Po vsakem posegu in anesteziji se potrebe po vitaminih skupine B močno povečajo. Tudi za pravilno prebavo sončnih žarkov so nujni vitamini iz te skupine. In prav vitamini B so na udaru novih pravil.
Dovoljene količine vitamina B6, ki ga sme vsebovati pripravek, so že prepolovili in v prometu so le izdelki, ki so prispeli na police pred to spremembo.
Omejitev količin prinaša tudi nekaj dobrega – ozaveščeni uporabniki bodo še bolj pod drobnogled vzeli kakovost izdelkov in jih bo pri tem zanimala predvsem biorazpoložljvost.
Pri vitaminih B to lahko pomeni velike razlike v učinkih, ker mora telo vsak zaužit vitamin najprej dodatno obdelati in prilagoditi svojim potrebam. Pri vseh, ki imajo težave z želodčno kislino, jetri ali mikrobiomom, je biorazpoložljivost vitaminov v telesu manjša od tega, kar je na ovojnini zapisano kot priporočeni dnevni odmerek. Če so sestavine aktivirane, pri vitaminih B pomeni, da so že prestali proces metilacije in tega ne bo treba dodatno narediti v telesu. Vitamin C bo najaktivnejši v liposomski obliki, vitamin D3 pa v kombinaciji z vitaminoma K in C.
Tudi pri drugih vitaminih je dobro iskati najaktivnejše oblike, ki omogočajo lažjo uporabo. Več znanja na tem področju pomeni prihranke, četudi ne izberemo najcenejših izdelkov. Nismo dovolj bogati za napačne izbire.
Eden od rednih bralcev revije, ki jo držite v rokah, nam je napisal, da je revija zanj »kot mesečni opomnik k bolj zdravemu načinu življenja«.
In gotovo je v vaši bližini še kdo, ki bi mu takšen »opomnik« prišel prav. Podarite mu naročnino! Znaša le toliko, kot imamo stroškov s pošiljanjem (9 € za 6 številk na leto), saj je revija sicer brezplačna.
NAROČILA: Znanje.zazdravje.net ali info@zazdravje.net


BESEDILO: TAMARA BUKOVEC
Kako bi lahko pričakovali, da bodo normativi za prodajo prehranskih dopolnil višji oziroma boljši, če smo kot družba popolnoma zatajili že pri standardih kakovosti za živila in semena. Namesto izbrane kakovosti danes kraljuje samo količina. Čim več za čim manj denarja! Redkokdo se vpraša, kaj pravzaprav »da v usta« in kakšno ceno bo zato plačalo njegovo telo.
Izvorni grej je napačna predpostavka, da naravni in sintezni vitamini v telesu delujejo enako. Tudi priporočene dnevne vrednosti, ki jih je določila stroka, so postavljene kot enotna številka, ne glede na to, iz katerega vira so. Pa je res enako, ali je vitamin iz naravnega vira ali ne?
Na papirju so številke enake, čeprav vsi vemo, da je zgodba v telesu popolnoma drugačna. In potem se pri številnih posameznikih kljub uživanju »kakovostnih« in pregrešno dragih prehranskih dopolnil
pojavi vprašanje, zakaj se ne počutijo bolje.
Ljudje se med seboj razlikujemo, vendar je ena stvar pri vseh enaka: telo ima raje kakovostne naravne vire vitaminov. Telo veliko hitreje in z bistveno večjim izkoristkom uporabi naravne snovi, ki jih že pozna.
Pomembno je poudariti, da so se potrebe vitaminov pri številnih posameznikih povečale. Nismo vsi enaki in pri nekaterih s presnovnimi težavami, oslabelim mikrobiomom ter šibkimi jetri se potrebe po določenih vitaminih močno povečajo.
Pri teh posameznikih je še toliko bolj pomembno, da zaužijejo kakovostne naravne vire vitaminov, saj z velikim odmerkov cenenih sinteznih vitaminov postanejo vprašljivi tudi pozitivni učinki uživanja. Vse, kar smo zaužili, moramo namreč tudi presnoviti, in pri cenenih sinteznih snoveh pri razkroju lahko nastane marsikaj škodljivega, kar telo bolj obremeni, kot mu pomaga.
Vitamini skupine B se zagotovo uvrščajo med najbolj iskane, saj je sploh v zadnjem desetletju vse več ljudi z motnjami presnove, nevrološkimi težavami in tudi resnimi bolezenskimi stanji, ki so posledica njihovega pomanjkanja.
Obstaja osem pomembnih vitaminov B, ki igrajo številne ključne vloge v telesu. Poleg proizvajanja energije in podpiranja razpoloženja so potrebni za
nastajanje rdečih krvničk, vzdrževanje imunskega sistema in še veliko več. Pomanjkanje kateregakoli vitamina B (zlasti folata in B12) ima lahko resne zdravstvene posledice.
Najučinkovitejša metoda za obnovitev pomanjkanja in vzdrževanje zdrave ravni vitaminov B v telesu je dopolnjevanje z metiliranimi vitamini B.
Metilirani vitamini B so v svoji biološko aktivni obliki in jih telo lahko neposredno in takoj uporabi. Nemetilirane vitamine B mora telo s posebnimi encimskimi procesi najprej pretvoriti v njihovo metilirano obliko. Pri ljudeh s presnovnimi motnjami in drugimi težavami je zato dodajanje aktivnih in biološko veliko bolj uporabnih metiliranih oblik precej bolj učinkovito.
ABSORBIRA VITAMINE B
Čeprav se vitamini B običajno absorbirajo skozi tanko črevo, se nekateri proizvajajo in absorbirajo predvsem skozi debelo črevo, kar kaže, da človeško telo z vitamini B, pridobljenimi iz prehrane in črevesne mikrobiote, morda ravna drugače. Med vitamine, ki jih telo lahko proizvede samo, sodijo:
vitamini B3 (niacin), B2 (riboflavin) in vitamin B12 (kobalamin). Seveda se je treba vprašati, zakaj je tako zelo izrazito pomanjkanje ravno teh treh vitaminov. Raznolika in obsežna mikrobiota je postala privilegij in ne normalo stanje. Žal življenjski slog večine ljudi uničuje številne bakterijske seve, zato vse bolj pogosto primanjkuje vitaminov skupine B.
Absorpcija vodotopnih vitaminov B navadno traja nekaj ur, če niso v bioaktivni metilirani obliki, pri kateri je absorpcija takojšnja, in kar je še bolj pomembno, izkoristek je bistveno večji od neaktivnih oblik enakih vitaminov.
Stroka v isti koš daje sintetične in naravne vire vitaminov, zato uporabniki nismo pretirano pozorni, kaj pravzaprav kupimo in zaužijemo. Pomembno je, da se izobrazimo in pred nakupom preverimo vire vitaminov, ki jih želimo oziroma potrebujemo. Skrbno preberimo deklaracijo, saj proizvajalci, za katere je kakovost pomembna, navedejo oblike vitaminov in njihov priporočeni dnevni odmerek. Izberimo bioaktivne oblike vitaminov, ki dosegajo dobro absorpcijo in visoko biološko razpoložljivost.



BESEDILO: ADRIANA DOLINAR
Ščitnični hormoni sodijo med primarne regulatorje energije v vsaki celici telesa. Dobro delovanje celic in posledično naše kipenje od energije in vitalnosti je zato močno povezano z dobrim delovanjem
ščitnice. Kako čutimo šibkost ščitnice, kateri so lahko vzroki in kako jo na naraven način podpreti?
KAKO OBČUTIMO ŠIBKOST ŠČITNICE
Znaki šibkega delovanja ščitnice so številni in lahko se pokažejo precej prej, preden težavo laboratorijsko potrdijo. Najpogostejši so pomanjkanje energije oziroma utrujenost, zlasti zvečer; upočasnjen metabolizem oziroma delovanje vseh celic; značilna je tudi nizka bazalna temperatura pod 36,6 oC. Veliko ljudi s šibko ščitnico nameri telesno temperaturo, merjeno pod pazduho (Broda Barnes test1) med 35,5 in 36,1 oC. Noge in roke so običajno mrzle in smo bolj občutljivi na mraz. Ob slabem delovanju ščitnice nas pogosto zebe, medtem ko drugih
1 https://www.drscottdenny.com/storage/app/ media/Barnes_Thyroid_Test.pdf
ne. Tudi tople nogavice so obvezna oprema, ko spimo. Kljub telesni aktivnosti in ustrezni prehrani zlahka pridobimo odvečne kilograme, in to ne le okrog trebuha. Težko tudi shujšamo. Redko se potimo. S telesno aktivnostjo pa se le počasi segrejemo. Navadno se tudi ob telesni aktivnosti ne počutimo dobro. Mišična masa se ob telovadbi slabo ali sploh ne krepi. Prebava je bolj lenobna. Prav tako je delovanje jeter šibko, pogosto je povišan holesterol, ki se lahko s krepitvijo ščitnice uravna. Počutje je depresivno, imunski sistem je šibak, povečana je občutljivost na infekcije. Prisotni so problemi s kožo: akne, izpuščaji, suha koža, žepki okrog oči in zabuhla koža. Prav tako na šibkost ščitnice kažejo tudi težave z lasmi: suhi, slamnati, krhki lasje in njihovo izpadanje. Značilno je izginjanje obrvi. Nohti so tanki, krhki in lomljivi. Lahko imamo težave z grlom in vratom, kot so smrčanje, težko požiranje in debel jezik, v katerega se pogosto ugriznemo. Ne prenesemo tesne obleke okrog vratu ali ogrlic. Lahko se pojavi tudi otečenost področja ščitnice.
K slabemu delovanju ščitnice pripomore zares veliko dejavnikov, med njimi so pomanjkanje ključnih hranil za nastajanje ščitničnih hormonov, pa tudi za pretvorbo T4 v aktivni hormon T3, kroničen psihičen in fizičen stres, uživanje nefermentirane soje ali hrane z ostanki pesticidov, pomanjkanje kakovostnih morskih živil v prehrani, težave s prebavili (pomanjkanje kisline, disbioza, puščajoče črevo, prehranske alergije … ), jetri, zobmi, uravnavanjem krvnega sladkorja, obremenjenost s toksini in škodljivimi sevanji (na primer z mobilnimi telefoni2…), pomanjkanje železa, vitamina D, nezadostno uživanje soli itd. Poglejmo podrobneje nekatere od njih.
NUTRIENTOV ZA PROIZVODNJO ŠČITNIČNIH HORMONOV
Celostni zdravniki, kot je dr. D. Brownstein, avtor številnih uspešnic za samozdravljenje, med poglavitne vzroke težav s ščitnico prišteva predvsem
2 An Exploration of the Effects of Radiofrequency Radiation Emitted by Mobile Phones and Extremely Low Frequency Radiation on Thyroid Hormones and Thyroid Gland Histopathology. Tasnim Alkayyali et. al.
znatno pomanjkanje joda. Tega ne moremo ustvariti sami, zato ga moramo nujno zaužiti v zadostni količini. Priporočljivo je, da pred dodajanjem večjih količin joda preverimo njegovo pomanjkanje s 24-urnim testom obremenitve z jodom v urinu. Opis testa najdete na spletni strani www.hakalalabs. com. Za učinkovito graditev ščitničnih hormonov pa so poleg joda nujni tudi preostali vitamini in minerali (selen, magnezij, cink, vitamini B, C, A …) ter aminokislina tirozin. Če jih primanjkuje, lahko to vodi do težav s ščitnico.
Halogeni elementi, kot so klor, brom in fluor, jodu preprečujejo vezavo na celične receptorje in tako med drugim ovirajo nastajanje ščitničnih hormonov. Klor najdemo v klorirani vodi; brom v pekovskih izdelkih, plastiki, pesticidih, gaziranih pijačah; fluor v zobnih kremah, vodicah, fluorirani soli, pitni vodi itd. Poleg njih škodijo ščitnici tudi druge toksične snovi, kot so živo srebro, svinec, arzen, PCB, DDT, dioksin, ftalati. Znano je, da živo srebro, ki se sprošča iz amalgamskih zalivk, ob vsakem žvečenju lahko povzroča težave tudi ščitnici. Kopiči se v njenem tkivu, povzroča poškodbe ter moti pretvorbo
T4 v aktivni hormon T3. Laboratorijske meritve lahko pokažejo visok T4 in nizek T3, pa tudi povečanje ščitničnih protiteles. Ta (anti TPO in anti TG) se lahko z varno odstranitvijo amalgamskih zalivk, dokazano,3 bistveno znižajo. Živo srebro povzroča tudi pomanjkanje selena, nujnega za proizvodnjo ščitničnih hormonov. Njegovo pomanjkanje je lahko sprožilec za nastanek avtoimunskega obolenja ščitnice – Hašimota.
Želodec za dobro delovanje (razgradnjo beljakovin) potrebuje dovolj kisline. Za njeno tvorbo so nujni jod, cink, vitamin B1, sol in voda. Jod torej ni pomemben le za dobro delovanje žleze ščitnice, ampak vseh žlez, vključno z želodčno sluznico. Če je želodčne kisline premalo, slabo prebavljamo beljakovine. Tako nam lahko posledično primanjkuje tudi aminokisline tirozin, ki skupaj z jodom tvori tiroksin – T4. Obenem ob pomanjkanju želodčne kisline lahko postanemo alergični na številne
3 Removal of dental amalgam decreases antiTPO and anti-Tg autoantibodies in patients with autoimmune thyroiditis. Ivan Sterzl et. al

“Kompleks za zdravje ščitnice”


zaužite beljakovine, tudi na tisto iz žit – gluten. Še več, protitelesa za gluten navzkrižno reagirajo s ščitnico in jo poškodujejo. Pomanjkanje želodčne kisline lahko slabi adrenalne žleze, ki telo podpirajo, tudi če je ščitnica šibka. Aminokislina tirozin namreč pomembno vpliva na raven hormonov adrenalne žleze. Posledično to lahko slabo vpliva na naše počutje in odziv na stres.
Za delovanje ščitnice sta pomembna zlasti meridijana vranice in želodca. Če imamo težave zlasti na prvih dveh zgornjih molarjih (mrtev zob, vnetje, karies pod plombo …), ki sta na teh meridijanskih poteh, je moten energijski pretok in posledično tudi delovanje ščitnice. Ta je lahko prizadeta tudi zaradi toksinov (na primer gliotoksinov), ki jih izločajo škodljivi mikrobi. Toksini namreč lahko potujejo naravnost od problematičnega zoba po meridijanih (prek fascij) do ščitnice.
Za učinkovito podporo ščitnice je pomembno poiskati vzroke za njeno slabo delovanje in jih čim prej odpraviti. Najprej je treba obvladati stres. Pogosto je nujno poseči tudi v kakovost prehrane – ta naj bo ekološka, bogata z jodom in preostalimi nutrienti, tudi koristnimi maščobami omega 3. Odpraviti moramo pomanjkanje železa in vitamina D. Na seznamu nujnih ukrepov je izboljšanje delovanja prebavil in jeter. Poskrbimo za razstrupljanje in manjšo izpostavljanje toksičnim snovem, predvsem škodljivim sevanjem. Če imamo amalgamske
zalivke, jih je treba varno odstraniti in opraviti z bakterijskimi žarišči v zobeh.
Za takojšno podporo proizvodnji in aktivaciji ščitničnih hormonov in s tem dvigu energije pa je telo treba bistveno oskrbeti s sinergijsko delujočimi hranili, kot so jod, L-tirozin, selen, cink, vitamini B1, B2, B3, C in A. Pri tem nam lahko pomagajo tudi kakovostni prehranski dodatki, kot je Thyroid Complex podjetja BioCare, ki vsebuje uravnotežene količine potrebnih hranil za zdravo delovanje ščitnice. Podjetje ima več kot 35-letno tradicijo izdelave kakovostnih in učinkovitih prehranskih dopolnil, ki nastajajo na podlagi razumevanja zdravja celostno in v sodelovanju z znanstveniki, nutricionisti in drugimi strokovnjaki. Podjetje v izdelkih uporablja nutriente z dobro biorazpoložljivostjo in brez nepotrebnih aditivov. Izbor hranil v posameznem prehranskem dodatku pa sinergijsko in kompleksno podpira telo pri obvladovanju težave.
Uravnajte svojo ščitnico in si povrnite energijo!
Priročnik Uravnajte ščitnico vam razkriva naravne rešitve za uravnavanje ščitnice. Naučite se prepoznati simptome in uporabite preverjene metode za izboljšanje svojega počutja in povrnitev energije.
Znanje.zazdravje.net

Dobro je, da prehranski dodatek za podporo šibki ščitnici vsebuje umerjen odmerek joda in tirozina za nežno podporo proizvodnji ščitničnih hormonov. Tako je mogoče odmerke po potrebi ustrezno prilagajati navzgor ali navzdol, seveda po posvetu z ustreznim strokovnjakom. V ustreznem ravnovesju naj bosta tudi selen in cink, ki podpirata pretvorbo T4 v aktivni hormon T3. Tudi vitamini B so nujni pri proizvodnji ščitničnih hormonov. Podpirajo celično presnovo in proizvodnjo energije. B3 obenem učinkuje na metabolizem serotonina, ki vpliva na počutje in apetit. Skupaj s kromom B3 regulira inzulin in podpira delovanje beta celic trebušne slinavke. Pri sladkorni bolezni tipa 2 pa vpliva na boljšo regulacijo krvne glukoze. Jod, cink in vitamin B1 pomembno sodelujejo pri nastajanju želodčne kisline. Številni nevede trpijo zaradi njenega pomanjkanja, kar slabi tudi ščitnico. Vitamin C med drugim podpira ljudi pod stresom, da se z njim lažje spopadejo. Koristno je, da pripravek vsebuje NAC (N-acetilcistein). Ta je še posebej priporočljiv za osebe s Hašimotovo boleznijo, ki trpijo zaradi raznih toksičnih obremenitev telesa, vključno z živim srebrom. NAC je prekurzor za nastajanje glutationa, pomembnega telesnega antioksidanta in čistilca. Podpira čiščenje živega srebra in zdravje sluznice črevesja. Cistein s selenom tvori selenocistein, pomemben ščitnični antioksidant. Za aktivacijo ščitničnih receptorjev je bistven tudi vitamin A, njegovo pomanjkanje namreč povezujejo s Hašimotovo boleznijo.
»Nikoli ne veš, koliko je dovolj, če ne veš, koliko je več kot dovolj«
(William Blake)

BESEDILO: IZ PRIROČNIKA ZBOGOM UTRUJENOST
Ko je vsega preveč in lučka, ki naznanja, da so naše baterije prazne, začne utripati, praviloma posežemo po kavi, pravem čaju, gvarani, kakavu ali energijski pijači.
Vsem tem napitkom je skupno to, da dejansko ne prinašajo energije, temveč telo prisilijo, da uporabi svoje rezerve prav z namenom, da se čim prej reši kofeina, ki smo ga zaužili. Tako stimulacija, če pretiravamo, zelo hitro preraste v posiljevanje in iritiranje.
Kofein je po svoji naravi pesticid (toksin iz družine alkaloidov), s katerim se rastlina varuje pred škodljivci. Ko ga zaužijemo, v telesu sprožimo preplah, ki začasno daje vtis, da smo polni energije.
Res je, stranski učinek tega je, da smo hkrati tudi bolj budni, zbrani in zmogljivi. Pospešitev metabolizma ima pa tudi številne koristne učinke na naš
imunski sistem, cirkulacijo in veselje do življenja.
Vendar ima kofein svoje meje, in več kot ga zaužijemo, manj učinka doseže- mo. Tako sčasoma pridemo do točke, ko kofein ne prime več in nam povečani odmerki pustijo le suha usta, občutljivost v želodcu, inkontinenco in več nervoze.

Seveda zgodba ni črno-bela. Različni viri kofeina se v svojem načinu delovanja razlikujejo. Rastline, ki vsebujejo kofein, hkrati prinašajo v telo tudi marsikaj koristnega. O tem, ali bomo od njih imeli več škode ali koristi, pa odločajo tudi kakovost, količina, način in čas uživanja.
Ker so kofeinska živila zelo globoko zasidrana v našo kulturo in navade, jih boste verjetno uživali tudi potem, ko boste prebrali knjigo Zbogom utrujenost – nova spoznanja pa vam lahko pomagajo da to storite bolj varno in učinkovito.
Marsikatero slabo lastnost poživil je možno omiliti, nepotrebno pretiravanje pa zamenjati z bolj zdravimi in enako učinkovitimi adaptogeni. Če boste preiskusili recepte, ki jih predlagamo, se zna zgoditi, da bo vaša potreba po kavi močno upadla.

BESEDILO: POVZETO IZ PRIROČNIKA RESNICE IN ZMOTE O ZDRAVJU ZOB
Dandanes večina zobozdravnikov pacientom zatrdi, da jim bodo amalgamske zalivke odstranili varno. Toda ko poslušamo zgodbe, kako stvari potekajo v praksi, ugotavljamo, da si zobozdravniki »varen postopek« predstavljajo zelo različno.
Za nekatere je varnost že to, da imajo separator, ki polovi izpljunjeni amalgam. Za druge je varnost zagotovljena s tem, da amalgamske zalivke odstranjujejo s posebnimi svedri, ne da bi pri tem zaščitili pacientova usta in sluznico.
To je poseg, ki lahko ob nepravilni izvedbi resno zamaje zdravje, zato se o tem, kako se ga bodo lotili, prepričajte, še preden sedete na zobozdravniški stol.
V ordinaciji, v kateri se z odstranjevanjem amalgamskih zalivk ukvarjajo vestno, še pred začetkom postopka poskrbijo za izolacijo, pri kateri zob z zaščitno opno ločijo od drugih ustnih površin. S tem preprečijo, da bi koščki amalgama, hlapi živega srebra in drobni delci zalivke prehajali v prebavila in dihala. Uporabljajo tudi posebne karbidne svedre, ki pri vrtanju ne ustvarjajo nevarnih drobnih delcev.
Poleg tega poskušajo z močnimi sesalniki uloviti čim več hlapov in koščkov zalivke v sesalni sistem, ki delce posesa v zbiralnik za nevarne odpadke.
Kot vidite na sliki levo, zaščita obsega tudi pokrivalo za pacienta in filter, skozi katerega diha, da se izogne drobnim delcem živega srebra, ki se sproščajo v zrak. Primerno zaščiteno je tudi vse osebje. Če ste izbrali ordinacijo, v kateri resnično poskrbijo, da je vse tako, kot smo opisali, boste veliko prihranili že pri prehranskih dopolnilih in večmesečnem razstrupljanju, ki je nujno po odstranjevanju amalgamskih zalivk s postopki, ki ne zagotavljajo tolikšne varnosti.
Če gre za večje zalivke ali za zalivke na zadnjih zobeh ali če že imate težave z imunskim sistemom, ščitnico, živčevjem …, je opisana zaščita nujna, če nočete tvegati dodatnih resnih zapletov zaradi živega srebra, ki se sprosti pri odstranjevanju zalivke.
Če ne želite biti zoprn izpraševalec in zasliševati osebja, je bližnjica, da poiščete zobozdravnike, ki imajo certifikat za biološko zobozdravstvo.
Če se vam zdi, da lahko prestanete tudi nekoliko

čim prej poloviti živo srebro, ki ga boste vdihovali in pogoltnili med posegom. Če vaš zobozdravnik opisanega posega ne more izvesti varno, se morate zavedati, da bo vaše telo doletel velik udar nevarnih snovi, na katere se bo moralo odzvati.
Zato naj vam v takšnih primerih nikoli ne odstranijo več zalivk v krajšem obdobju ali celo sočasno. Najbolje je, da med odstranjevanjem vsake posamezne zalivke mine vsaj nekaj mesecev.
POVEZUJEMO MEDICINO IN ZOBOZDRAVSTVO.
Imate v ustih še kakšno amalgamsko zalivko in bi jo želeli varno odstraniti?
V Ustni Medicini odstranjujemo amalgamske zalivke na varen in telesu prijazen način po SMART protokolu, ki je skupek varnostnih ukrepov za zmanjšanje izpostavljenosti živemu srebru med odstranjevanjem amalgamskih zalivk.
Naročite se na prvi pregled: info@ustna-medicina.com / (01) 232 32 35

BESEDILO:
SANJA LONČAR
Davek na pretirano rabo antibiotikov je, da skoraj ni mogoče najti bakterije, ki ne bi razvila odpornosti proti kateremu izmed razpoložljivih antibiotikov.
Tako je zdravilo, ki je pred stoletjem veljalo za najboljšega, kar jih premore sodobna medicina, danes postalo povzročitelj vse večjega števila okužb s smrtnim izidom.
Svetovna zdravstvena organizacija (WHO) svari, da danes zaradi bakterijskih okužb umre več ljudi, kot jih je pred iznajdbo antibiotikov.
Dokler so bili antibiotiki namenjeni zdravju, je še šlo, ko pa smo jih začeli uporabljati zaradi večjega dobička, se je zalomilo. Največji porabnik antibiotikov je danes živinoreja. V razmerah kot v koncentracijskih taboriščih, kar je najustreznejši opis za bivanje večine živali, ki jih danes redijo za hrano, je nemogoče ostati zdrav brez obsežne uporabe razkužil in zdravil. Trenutno je znano, da veterinarska
uporaba antibiotikov presega uporabo pri ljudeh za približno od dvakrat do trikrat. Ostanki antibiotikov se z izločki živali selijo tudi v okolje, zato imajo bakterije velik poligon, na katerem »trenirajo« svojo odpornost proti vsem znanim antibiotikom.
Bakterija Staphylococcus aureus je bila pri tem še posebej iznajdljiva in je razvila odpornost ne le proti meticilinu (od tod tudi ime MRSA), temveč tudi proti drugim antibiotikom – dikloksacilinu, nafcilinu in oksacilinu.
Raziskave kažejo, da je proti antibiotikom postalo odpornih do deset odstotkov bakterij iz te skupine. Če bakterijo gostimo nekje na koži in sluznicah, še vedno ni nevarno. Zaplete se, ko imunski sistem močno upade ali je telo poškodovano (na primer po operacijah) in bakterija skozi rane, diagnostične sonde, katetre ... najde pot v kri, srce in druga tkiva. Takrat govorimo o smrtno nevarni bolnišnični okužbi z bakterijo MRSA.
Če je na voljo še kakšna oblika antibiotika, proti kateri bakterija ni razvila odpornosti, imamo srečo. Če je ni, sodobna medicina nima rešitve za zaplete, zato se tudi število smrti, ki jih povzroča MRSA, strmo vzpenja.
Ta stavek vam v številnih bolnišnicah in domovih za ostarele lahko reši življenje. Odstotek krvnih okužb, ki jih povzroča MRSA, se namreč od države do države zelo razlikuje, predvsem glede na to, koliko osebje v bolnišnicah in domovih za ostarele upošteva higienske standarde.
V Evropi so najbolj varne danske in nizozemske bolnišnice, kjer jih je med vsemi krvnimi okužbami le 1,6 odstotka povzročila MRSA. Na Švedskem je MRSA povzročila dva odstotka okužb, v Avstriji 3,1 odstotka, na Hrvaškem 66,7 odstotka, v Makedoniji pa 80,8 odstotka.
Gre za uradne podatke WHO, med katerimi žal ne najdemo podatkov za Slovenijo. Iz izkušenj v minulih letih vemo, da imamo žal tudi pri nas sramotno visoko statistiko bolnišničnih okužb.
Na srečo obstaja več naravnih strategij, s katerimi lahko omejimo ali celo zatremo razvoj bakterije MRSA v telesu.
V knjigi Ščepec rešitve smo pisali o močeh cimeta, črne kumine, klinčkov, kopra, koromača, lovorja, muškatnega oreščka, majarona, rožmarina in šetraja, ko gre za bakterije iz rodu stafilokokov. Poprova meta pa je dokazano učinkovita tudi pri bakteriji MRSA.
Tudi propolis je pokazal dobre učinke pri tej bakteriji, posebej če jo ujamete, dokler je še na površini kože in sluznic.
Svojo notranjo obrambo pa lahko natreniramo, da je kos tudi takšnim izzivom. To potrjujejo rezultati raziskave, ki so pokazali, da je urejanje mikrobioma najboljša bližnjica, da uničimo bakterijo MRSA.
Specifični mikroorganizmi namreč izločajo posebne snovi, bakteriocine, ki lahko na različne načine delujejo proti patogenim bakterijam. Nekateri destabilizirajo celično membrano tarčne bakterije, drugi zavirajo sintezo celične stene ali motijo procese znotraj bakterije. Rezultat je vedno enak, patogena bakterija se upočasni ali onemogoči.
To je zelo koristno, ker omogoča zdravljenje okužb brez vpliva na stanje koristnih bakterij.
Učinek so testirali na Multi EM fermentu, ki vsebuje specifične kombinacije 31 sevov efektivnih mikroorganizmov. Poskus in vitro je pokazal, da so
Odpornost proti antibiotikom je ena od glavnih groženj javnemu zdravstvu in razvoju.
Bakterije, odporne proti antibiotikom, so leta 2019 povzročile 1,27 milijona smrti, posredno pa imajo »na vesti« 4,95 milijona smrtnih žrtev na leto. To je več, kot je seštevek vseh vojn, ki se trenutno odvijajo na našem planetu.
Vir: WHO
izbrani mikroorganizmi zelo učinkovito eliminirali bakterijo Staphylococcus aureus. Delovanje je bilo očitno v pičlih dveh urah. Pri velikem številu pagotenov pa so mikroorganizmi za uničenje zlovešče bakterije potrebovali osem ur.
Zaradi naraščajoče odpornosti bakterij proti antibiotikom potekajo številne raziskave uporabe bakteriocinov kot alternativnih terapevtskih sredstev. Največja prednost takšnega pristopa je, da lahko patogene omejimo ali celo eliminiramo brez kolateralne škode, ki jo utrpimo, če posežemo po sinteznih antibiotikih.

Večstopenjsko fermentiran eliksir z edinstvenim spektrom 31 Efektivnih Mikroorganizmov in biodostopnimi hranili iz 31 zelišč.
Za podporo imunskemu sistemu. 20 milijard dobrodejnih EM v dnevnem odmerku 20 ml.
+ imunski sistem | + prebava | + celična zaščita + energija | + antioksidant | + koncentracija + razpoloženje
Uglasite mikrobiom!


BESEDILO: SABINA TOPOLOVEC
Cena kepice sladoleda je v nekaj letih dosegla stoodstotno rast. Medtem ko se mnogi pritožujejo nad vse višjimi cenami, bi se v resnici morali vprašati, kaj nad goro sladkorja in kopico aditivov poreče naše zdravje!
Ste kdaj sami pripravljali sladoled? Na naši spletni strani www.zazdravje.net lahko poiščete kar nekaj navdihov zanj. Kaj pravite na jagodni sladoled le z dvema žlicama javorovega sirupa ali veganski sladoled povsem brez sladkorja? V obeh primerih za izjemen okus poskrbijo pristna naravna živila, kot so kakovostno sadje, oreščki in smetana, za res izdatno merico antioksidantov pa dodane začimbe. Pravzaprav je domač sladoled skorajda zdrav, cenovno pa krepko pod sladkornimi kepicami iz slaščičarn. Ustvarite ga lahko brez vsakršnih slaščičarskih izkušenj in dragih aparatur.
Lahko pa gre še preprosteje. Moja otroka zelo uživata ob zamrznjenih zdrobljenih malinah. Pravita, da so še slajše od svežih in popoln nadomestek sladoleda. Sladke, najbolj pristnega sadnega okusa in najbližje izvornemu živilu. Preizkusite jih lahko tudi pomešane z nekaj stepene sladke smetane z vaniljo in sesekljano temno čokolado.
Tudi domače lučke, za pripravo katerih v preprostih modelčkih zamrznemo gosti sok, so odličen nadomestek. »Recepturo« poznam še iz študentskih časov, ko smo iz enega litra Fructalovega gostega soka ustvarili vsaj ducat lučk. Ne vem, kje in kako so takrat zrasle tiste breskve in marelice, vem pa, da sadje in zelenjavo danes gojijo v povsem drugačnih razmerah. Številne rastline za vznik in vzgojo že desetletja ne potrebujejo več ne zemlje ne sonca. Ne gre le za pesticide!
In tako se poleti pod pretvezo varovanja zdravja vse bolj izogibamo sonca, ki ga ne najdemo več niti v sadju in zelenjavi, če ju ne pridelujemo sami. To na embalaži seveda ni navedeno, najdemo lahko le energijsko vrednost, vsebnost mikrohranil in poreklo. Če želimo živilo brez ostankov pesticidov, izbiramo med ekološko in biodinamično pridelavo, ki sta na izdelkih označeni z ustreznimi certifikati.
Če torej želite sladoled z visoko vsebnostjo biofotonov (energijo sonca) in brez ostankov pesticidov, je možno poreklo le eno – biodinamična pridelava, ki jo na izdelkih prepoznate pod certifikatom Demeter. Tudi v Sloveniji imamo nekaj kmetij, ki hrano pridelujejo po načelih biodinamike, ter številna biodinamična društva, v katerih si člani sami pripravljajo in izmenjujejo pripravke ter znanje s tega področja. Biodinamično kmetovanje pomeni precejšen korak naprej od ekološkega, saj ne gre zgolj za opustitev spornih pesticidov, temveč za precej tesnejši stik z zemljo, zakoni narave in pravo izvirno kodo. Ne preseneča, da se zato za takšno kmetovanje odločajo le najbolj »navdušeni«, ki so se pripravljeni učiti novega in kmetovanje obrniti precej na glavo.
Dobra novica je, da nekaj tovrstne hrane lahko poiščemo tudi na oddelkih za zdravo prehrano. Zapomnite si ime certifikata Demeter, ki zagotavlja največjo vsebnost antioksidantov in – pomembno – način pridelave, pri katerem je hidroponika (gojenje zelenjave brez zemlje) prepovedana.
Z izvrstno sadno kašico, namenjeno najmlajšim, pa lahko napolnite tudi modelček za lučko in malčka razveselite s sladoledom brez kančka spornih dodatkov. Takšne so denimo kašice Mogli, ki stanejo manj od kepice sladoleda! Izbirate lahko med okusi malina-rabarbara-banana, borovnica-banana-jabolko in številnimi drugimi. Vse njihove kašice so brez ščepca dodanega sladkorja in konzervansov!
Otroke na zdrave sladice najlažje navadimo, če v njih uživamo tudi sami. Že omenjene sadne kašice za otroke lahko uporabimo tudi kot osnovo za domač sladoled.
Sladoled s tropskim pridihom
» 1 vrečka sadne kašice Mogli z mangom, gvajavo in banano
» 1 pločevinka kokosovega mleka
» lupinica in sok 1 bio limete
» 1 žlička svežega ingverjevega soka
» noževa konica prave vanilje
» 1 žlica medu ali javorovega sirupa
» nekaj svežega ali vloženega ananasa
Sestavine pomešamo in maso nadevamo v nizek model. Postavimo v zamrzovalnik in po eni uri



premešamo. Zamrzujemo še eno uro in sladoled je pripravljen. Po želji vanj vmešamo še nekaj drobno zrezanega ananasa.


Sladoled z okusom jagode in piškotka
» 1 vrečka sadne kašice Mogli z jagodo, jabolkom in banano
» 250 ml grškega jogurta
» 2 žlici javorovega sirupa
» ½ žličke cimeta
» 1 zavitek maslenih piškotov Mogli
Vse sestavine razen keksov premešamo in nadevamo v nizek pekač. Postopamo enako kot pri prejšnjem receptu. Piškotke grobo sesekljano in jih vmešamo, tik preden sladoled postrežemo.
Tako se najbrž sprašujejo mnogi, ki nasedejo na nekoč bolj logična zdravstvena priporočila v smislu »zdrava kmečka pamet«, »vsega po malem« in podobno. A ko pogledamo kmete, ki po cesti drvijo v ogromnih klimatiziranih in drugače najbolj sodobno opremljenih vozilih, ki le še spominjajo na traktor, sami pa imajo vsaj 30 kilogramov preveč, se hitro vprašamo, kam je izginila kmečka pamet. Vsega po malem pa dandanes hitro vodi v obilje predelane hrane. Ta namreč prednjači in mednjo se uvršča tudi sladoled. Malo sladoleda, malo čipsa, malo »pohančka«, le malo pa tudi solate in sadja na koncu preprosto ne vodi drugam kot v malo (premalo) zdravja. In tega našim najmlajšim (pa tudi nam, odraslim) vse bolj manjka. Zato sta omenjeni »priporočili« že davno izpeti. Skrajni čas je torej, da vpeljemo novo zdravo pamet, pogledamo, kako v danih razmerah jesti najbolj kakovostno in preprosto poskrbeti, da bo zdravih prehranskih izbir – veliko!
Ne bo zdravo za želodec, bo pa za denarnico!
S 1. julijem je stopil v veljavo novi tarifni sistem za omrežnino, s katerim nas, kot navajajo, »želijo stimulirati, da s prilagajanjem odjema prispevamo k optimizaciji distribucijskega sistema«.
Prevedeno bolj po domače: da ne bi delali nove infrastrukture, so se domislili, da potrošnike stimulirajo, če elektriko uporabljajo takrat, ko je je preveč, in jih močno udarijo po prstih, če jo želijo uporabljati takrat, ko je poraba velika in sistem obremenjen.
Večina potrošnikov se sploh ne zaveda, kako bo to vplivalo za račun za elektriko. Nove cene elektrike bodo v večji meri plačilo infrastrukture. Do zdaj je bila razlika med poceni in dražjo elektriko le približno deset odstotkov. Cene samega energenta se tudi zdaj ne bodo spremenile, vendar se bo močno spremenila omrežnina.
Po novem bodo razlike med uporabljanjem elektrike v najnižji in najvišji tarifi (ki jih bo odslej pet) ogromne. Izračun bo izhajal iz uporabljene moči v določenem časovnem obdobju, ta pa je tako zapleten, da še najbolj usposobljeni ne znajo točno izračunati, kako bo njihov račun videti v praksi.
Tarifne postavke omrežnine glede na uporabljeno moč (EUR/kW/mesec) pa bodo v tarifni skupini 1 naslednje:
» v 5. tarifi 0,00000
» v 4. tarifi 0,00082
» v 3 tarifi 0,01858
» v 2. tarifi 0,12667
» v 1. tarifi 0,65940
Kot vidite, je tarifa prvega razreda za več kot 800-krat višja kot tarifa četrtega razreda.

Ne, nismo se zmotili, 800-kratnik bo uporabljen pri obračunu za elektriko, ki jo bomo od novembra do februarja uporabljali med 7. in 14. uro ter med 16. in 20. uro.
Kot vidite, časi postajajo zelo zahtevni. Družba je na prelomnici, v igri pa je veliko možnih scenarijev. Verjamemo v moč povezanih in srčnih ljudi, ki želijo zgraditi boljšo družbo za vse nas in naše zanamce.
Naše glasilo je hkrati glas številnih nevladnih organizacij, za katere vrata velikih medijev niso odprta.
Podprite našo glasnost, omogočite, da bo te novice bralo še več ljudi in da boste tudi sami v našem informacijskem središču lahko dobili še več dragocenih in potrebnih informacij.
Vsaka izpolnjena zahteva za namenitev dela dohodnine je za nas veliko več kot le nekaj evrov, ki jih prinaša. Je predvsem potrdilo, da ima to, kar


počnemo, smisel. Da vam ni vseeno. In da so številne neprespane ure, ki jih vlagamo v ta projekt, seme, iz katerega bo vzniknilo nekaj dobrega.
Če imate elektronsko digitalno potrdilo, lahko zahtevo za namenitev dohodnine oddate tudi elektronsko. Še hitreje gre, če preprosto odtrgate, izpolnite in pošljete.

Zaradi zaščite osebnih podatkov prosimo, da stran odrežete, prepognete in zalepite.
Planina na Pohorju 44 3214 Zreče
Lani je 1640 oseb, ki so nam donirale delež dohodnine, omogočilo, da te brezplačne novice redno bere več kot 100.000 ljudi in da se lahko ukvarjamo s številnimi pobudami, od katerih bo odvisna prihodnost vseh nas. Pridružite se našim donatorjem, da bomo lahko skupaj naredili še več.
Prosimo, namenite nam del svoje že vplačane dohodnine, pošljite nam nekaj znamk A, donirajte, sebe ali koga drugega naročite na naše novice, delite naše objave, prebirajte naše priročnike. Držimo skupaj, za varnost vseh nas.




Skenirajte QR KODO ali odprite: www.zazdravje.net/donacije


(ime in priimek davčnega zavezanca)
(podatki o bivališču: naselje, ulica, hišna številka)
(poštna številka, ime pošte)
(davčna številka)
(pristojni finančni urad, izpostava)
ZAHTEVA za namenitev dela dohodnine za donacije
Ime oziroma naziv upravičenca
Društvo Ognjič - za naravno in kvalitetno življenje
v/na dne
Davčna številka upravičenca
Odstotek (%)
1 % 49145738
(podpis zavezanca/ke)

Kljub vsem zapletom, plesnim, polžem, bramorjem, toči, suši, mrazu ... smo člani društva Samooskrbni.net s skupnimi močmi to leto veliko pridelali.
BESEDILO: ALENKA ŠOŠTARIČ
Pravimo, s skupnimi močmi, ker je letos zaživela skupinska obdelava njiv na večjih lokacijah, pri izpadu pridelka pa smo našim članom pomagali s sadikami SOS. Tudi presežni pridelki so romali tja, kjer je narava pokazala zobe.
Na vrsti je pospravljanje pridelka, česar se prav tako lotevamo s skupnimi močmi. Številni naši člani so se že izmojstrili v fermentacijah in pripravi pesta.
Pri zelenjavi raziskujemo, kako se izkaže vlaganje pod tlakom, ki omogoča, da vložimo zelenjavo brez kisa in varno shranimo tudi živalske beljakovine brez zamrzovanja in sušenja.
Zelene ostanke smo se naučili predelati v gnojila in sredstva za varstvo rastlin. Več timov pripravlja svoj lastni bokaši, s katerim fermentira odpadke in si zagotavlja hitra gnojila za rastline. Hrbtenica ne trpi, rastline pa uživajo.

Ste vedeli, da je tudi iz ostankov zelenjave mogoče narediti odličen kis? Pri nas res nič ne gre v nič.

Jesensko trgatev pa bo že tradicionalno spremljala skupna predelava v sokove in gurmanske marmelade. Vsak dan postajamo vse bolj samooskrbni ... in brezskrbni. Pridruži se nam!
Ker je vlage dovolj, nam vsaj zelenih rastlin ne primanjkuje, zato pripravite čim več pesta, živila pa fermentirajte in vlagajte s čim manj sladkorja in soli. Preverjene recepte preberite v knjigi

Samooskrbna shramba.
Knjigo lahko prelistate in naročite na naslovu: https://znanje.zazdravje.net

kod prihajajo »slovenska« semena?
BESEDILO: SANJA LONČAR
To sezono z vseh strani slišimo, da korenovke zelo slabo rastejo, da iz vrečke zelja zraste ohrovt, da je rumeno korenje dejansko zraslo oranžne barve, grmičaste buče pa plezajo. Se sliši znano?
S semeni korporacij je vse več težav, kot da nas želijo pripraviti na nove genomske tehnike, s katerimi nas bodo »rešili« vseh težav na vrtu. Veliko dela nas čaka, saj samooskrbnost in prehranska suverenost visita na nitki.
Tako kot na vseh področjih sta se znanje in natančnost umaknili kapitalu.
Ko na vrečki vidimo zapisano, da je seme iz selekcije ptujskega centra, se prehitro razveselimo, da gre za slovensko seme.
V praksi gre za vzgojo osnovnega materiala, ki ga res pripravijo strokovnjaki našega semenarskega centra na Ptuju, a ta gre nato v roke pridelovalcem (po vsem svetu), ti pa potem pridelujejo semenski material za trg, na katerem ta semena kupimo tudi v vrečkah s slovenskimi imeni.
Tudi semenski krompir z domačimi imeni pogosto pridelajo tam, kjer je ceneje in bolj varno zaradi bolezni. Po ocenah poznavalcev manj kot odstotek vseh uporabljenih semen zares pridelajo v Sloveniji.
Kako se bo semenski material, ki je zrasel v rastlinjakih na Nizozemskem, znašel na slovenskih tleh, pa je vprašanje, s katerim si pridelovalci semen ne belijo glave.
Tam, kjer delajo strojno in sledijo le dobičku, dejansko večino dela opravijo stroji. To pomeni, da opazovanje rastlin, izločanje neustreznih, selekcija semen z najboljših rastlin in izbira semen z najboljšega mesta na rastlini ne pridejo v poštev.

Obisk poskusnih polj Semenjalnice - v praksi se najbolj vidi, katere sorte so kos sodobnim vremenskim izzivom.
Strokovnjaki so nam razkrili še eno bližnjico: da glave zelja ne zgnijejo čez zimo, jih pozno posejejo, da zimo dočakajo le v obliki listov, tako takšne rastline spomladi zacvetijo in je cenejše pridelati seme. Pozabili so le, da bo zelje, ki je zacvetelo, ne da bi pred tem naredilo glavo, zelo verjetno tudi v naslednji sezoni »pozabilo«, kako se delajo trde in kompaktne glave.

Nekaj dni po našem obisku, je poskusni center doživel uničujočo točo. Še dokaz več, da bomo za ohranjanje semen potrebovali sistem ki deluje na večjih lokacijah.
BREZ LASTNIH SEMEN
NE BO SAMOOSKRBE
Vse več je ljudi, ki se zavedajo, da brez lastnih semen ne bo samooskrbe. Vsi doživljamo podobno –to, kar vznikne iz domačih, avtohtonih, tradicionalnih semen, je veliko bolj vitalno, zdravo in odporno.
Pot do domačega semena pa ni preprosta. Vaši babici je bilo lažje. Cela vas je gojila le eno sorto zelja ali fižola, zato so se lahko nekatere sorte ohranile neskrižane skozi stoletja.

Cilj: S skupnimi močmi, do ljudske semenske knjižnice.
Danes pa je obilje na vrtu dejansko zelo otežilo pridelavo lastnih semen. Treba je vedeti, kaj je samooprašno, kaj potrebuje opraševalca, kaj se lahko križa, kdaj in s katerega dela rastline seme pobrati itd.
Člani društva Samooskrbni.net v sodelovanju z Eko civilno iniciativo Ekoci in Semenjalnico želimo čim več znanja in starih sort rešiti pred propadom. Zato se povezujemo, načrtujemo skupne aktivnosti, pospešujemo prenos znanja, pripravljamo pobude za MKGP itd.
Na blogu Samooskrbni.net lahko najdete več informacij, kako se pravilno lotiti pridelave in pridelati kakovostno seme.
ZA PRIHODNOST
Ko so to vprašali enega finančnih strokovnjakov, je brez obotavljanja dejal – prijatelji.
V negotovih časih je povezanost najboljša varnost. Posameznik je ranljiv, sam ne zmore veliko in tudi njegovo znanje je omejeno. Modrost, izkušnje in mišice tudi ne gredo skupaj, zato smo najboljši, ko sodelujemo. Združeni zmoremo veliko več, hitreje in lažje.
S to miselnostjo v Sloveniji že poteka veliko različnih projektov, ki omogočajo, da se ljudje spoznavajo, povezujejo, izmenjujejo izkušnje in znanje. Dobra stran vse večjega zavedanja, ko smo priča tektonskim spremembam na vseh področjih življenja, je brca, da pospešimo tempo.
Marsikaj smo uspešno pozabili, izgubili ali uničili v pičlih nekaj desetletjih. Ponovna graditev zahteva več časa kot uničenje, je pa mogoče, nujno in hkrati navdihujoče za vse, ki so se odločili stopati po tej poti.
Skupaj smo lažje samooskrbni
s hrano, semeni, zeliščnimi pripravki ...
Brez večletnih poskusov in učenja na lastnih napakah!
Pridruži se nam!
Ponujamo bogato znanje in izkušnje vsem, ki so pripravljeni zavihati rokave. Povezani smo v veliko samooskrbno mrežo s skoraj 500 člani.




